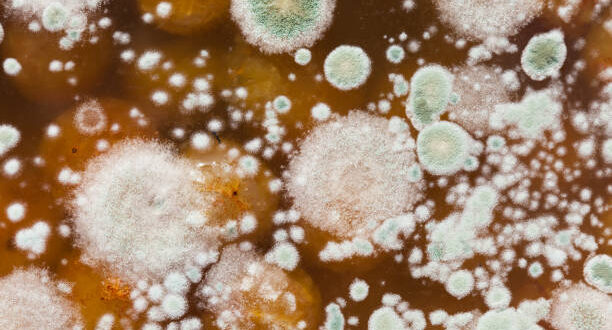

बारिश का मौसम हो या नमी से भरा कमरा—इन स्थितियों में फंगस (Fungus) सबसे तेजी से पनपता है। कई बार हम इसे दीवारों या कपड़ों की बदरंग सतह समझकर नजरअंदाज कर देते हैं, लेकिन यही फंगस हमारे स्वास्थ्य के लिए खतरनाक बीमारियों की वजह बन सकता है। एम्स (AIIMS) के माइक्रोबायोलॉजिस्ट डॉ. नीरज सिंह बताते हैं, “घर के नम कोनों और गलत सफाई की आदतों के कारण फंगल स्पोर्स हवा में फैल जाते हैं, जिससे त्वचा, फेफड़े और आंखों से जुड़ी बीमारियां हो सकती हैं।”
घर में कहां-कहां फंगस पनप सकता है?
बाथरूम की टाइल्स और ग्राउट:
हमेशा गीले रहने की वजह से यहां फंगस, खासकर ब्लैक मोल्ड, तेजी से फैलता है।
एयर कंडीशनर और कूलर के फिल्टर:
इनमें जमा नमी और धूल फंगल ग्रोथ के लिए उपयुक्त माहौल बनाती है।
रसोई के सिंक और कैबिनेट्स:
पानी की लीक और अंधेरा फंगस के पनपने के लिए परफेक्ट कॉम्बिनेशन है।
पुराने जूते, बैग और लकड़ी के फर्नीचर:
लंबे समय से इस्तेमाल न होने वाली चीजें फंगल संक्रमण का स्रोत बन सकती हैं।
फंगल संक्रमण के लक्षण:
त्वचा पर लाल चकत्ते या खुजली
पैरों की उंगलियों में पीलापन या बदबू
सांस में तकलीफ (फेफड़ों में फंगस)
आंखों में जलन या धुंधलापन
बार-बार बुखार (क्रॉनिक फंगल इन्फेक्शन)
फंगस से बचाव के उपाय:
घर की नमी नियंत्रित रखें – ह्यूमिडिटी 50% से कम हो
बाथरूम और किचन को साफ और सूखा रखें
AC और कूलर के फिल्टर समय-समय पर साफ करें
पुराने और गीले कपड़ों को तुरंत धोकर सुखाएं
फंगल इन्फेक्शन होने पर तुरंत डॉक्टर से संपर्क करें
यह भी पढ़ें:
 Business Sandesh Indian Newspaper | Articles | Opinion Pieces | Research Studies | Findings & News | Sandesh News
Business Sandesh Indian Newspaper | Articles | Opinion Pieces | Research Studies | Findings & News | Sandesh News